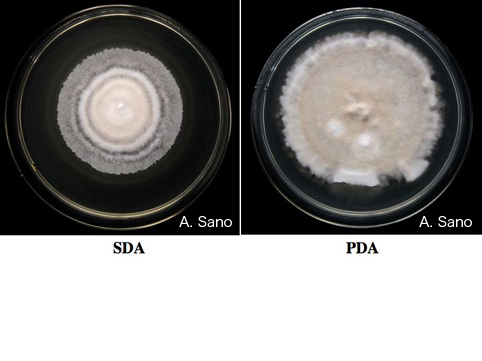

|
|
Histoplasma capsulatum var. capsulatum Potato dextrose agar(right) and Sabouraud dextrose agar(left), 25℃, 60 days. Biosafty level 3. ポテト・デキストロース寒天(右)およびサブロー・デキストロース寒天(左),25℃,60日.バイオセフティレベル3 |
|
|||
| |
| 〒260-8673 千葉市中央区亥鼻1-8-1 電話:043-222-7171(代表) FAX:043-226-2486 Copyright 1999 Chiba University Research Center for Pathogenic Fungi and Microbial Toxicoses |